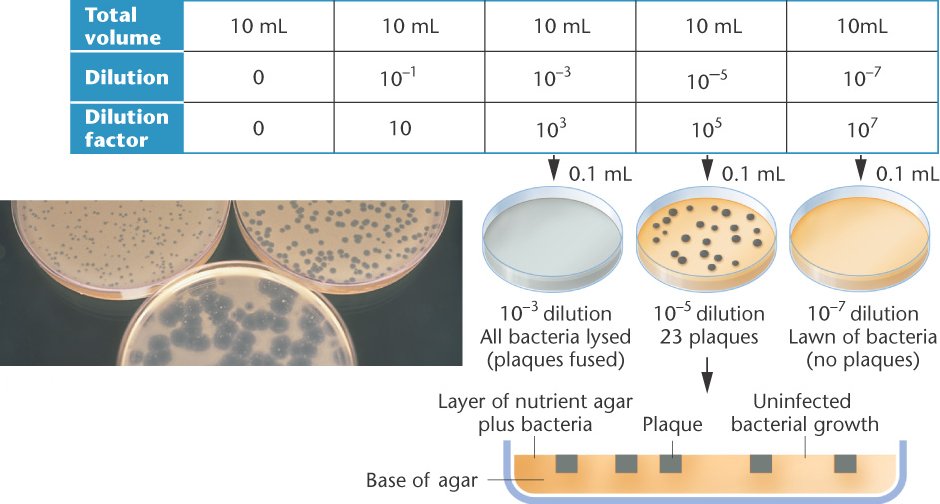
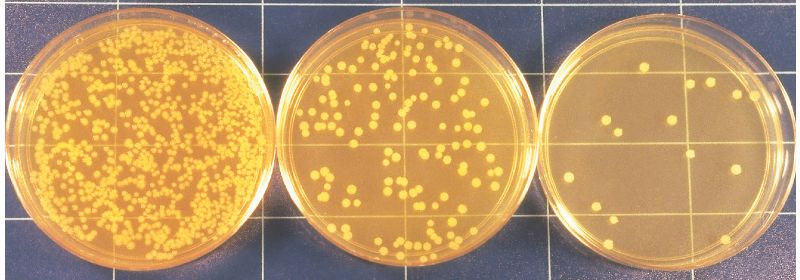

06_01-exponential_growth

06_01u-exponential_growth

06_02-serial_dilution

06_03-prototroph

06_04-U-tube

06_05-pilus

06_06-conjugation

06_07-conjugation_transfer

06_08-conjugation_map

06_09-conjugation_order

06_10-conjugation_integration

06_10-conjugation_integration2

06_11-conjugation_excision-cells

06_11-conjugation_excision

06_11-conjugation_excision3

06_11-merozygote

06_12a-plasmid

06_12b-plasmid

06_13-transformation

06_13-transformation2

06_14-T4

06_15-T4-cycle
06_16-lawn

06_16-plaque_assay

06_16-plaque_dilution

06_17-transduction

06_18-transduction_generalized

06_19-phage_recombination

06_20-intragenic_recombination

06_21a-complementation

06_21b-complementation

06_22-cistron

06_23-deletion_testing

06_24-deletion_mapping

06_25-T4_rII_map

06_T01-T-even-phage_mutations

06_T02-mixed_infection

T-even-phage_mutations.html

T4-cycle.html

T4.html

T4_rII_map.html

U-tube.html

cistron.html

complementation-no.html

complementation.html

conjugation.html

conjugation_excision.html

conjugation_excision3.html

conjugation_integration.html

conjugation_integration2.html

conjugation_map.html

conjugation_order.html

conjugation_transfer.html

deletion_mapping.html

deletion_testing.html

exponential_growth.html

intragenic_recombination.html

mixed_infection.html

phage_recombination.html

pilus.html
plaque_assay.html

plaque_dilution.html

plasmid.html

prototroph.html
serial_dilution.html

transduction.html

transduction_generalized.html

transformation.html

transformation2.html
